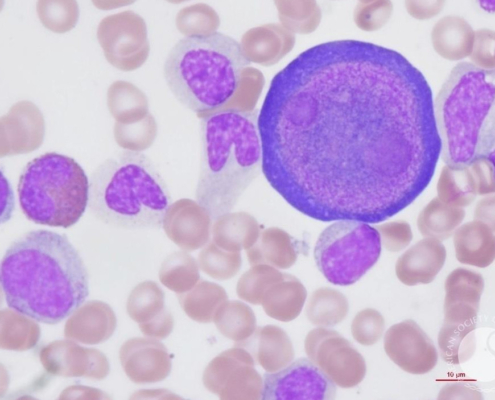

Εβδομαδιαία ανασκόπηση με άρωμα εκλογών…
Επιμέλεια: Πάλλας Βαγγέλης Δημοσιογράφος…

Κοινωνικό τηλεοπτικό μήνυμα για τον εμβολιασμό απέναντι στην εποχική γρίπη και την cοvid 19
Πρόσφατα παρουσιάστηκε το κοινωνικό…
https://peripteron.eu/wp-content/uploads/2023/01/GEN.jpeg
363
700
Emmanuel
https://peripteron.eu/wp-content/uploads/2023/11/peripteronSite.png
Emmanuel2023-01-21 06:12:112023-01-20 19:18:08Ανασκόπηση ΓΕΝ 2022
https://peripteron.eu/wp-content/uploads/2022/12/Screenshot-2022-12-25-at-1.26.00-PM.png
462
700
Emmanuel
https://peripteron.eu/wp-content/uploads/2023/11/peripteronSite.png
Emmanuel2023-01-05 06:12:022023-01-04 21:16:38Καλή χρονιά!
Ένας Χρόνος peripteron.eu…
Ένα καθαρά δημοσιογραφικό site με πλουραλισμό…
https://peripteron.eu/wp-content/uploads/2022/06/mqdefault.jpeg
225
400
Emmanuel
https://peripteron.eu/wp-content/uploads/2023/11/peripteronSite.png
Emmanuel2022-07-31 06:12:442022-07-30 17:40:07Ιστορικό Αρχείο ΕΥΔΑΠ
Παγκόσμια Ημέρα Νερού 2022 “Υπόγεια Νερά – Κάνοντας το αόρατο ορατό”
H 22α Μαρτίου έχει καθιερωθεί ως η Παγκόσμια…

ΕΥΔΑΠ: Ένα νέο μοντέλο ολοκληρωμένης ψηφιακής εξυπηρέτησης για κάθε πελάτη
Στην ΕΥΔΑΠ εμπλουτίζουμε συνεχώς…

Πρεμιέρα για τα πρώτα 46 ηλεκτρικά λεωφορεία στην Αθήνα
Στο πρώτο δρομολόγιο των νέων ηλεκτρικών…

Τι προνοεί η πρόταση νόμου του ΑΚΕΛ για φορολόγηση των υπερκερδών των τραπεζών
Πρόταση νόμου για φορολόγηση των…
Παρβοϊός: Ποιο είναι το χαρακτηριστικό σύμπτωμα σύμφωνα με παιδίατρο – Τι λέει για τις εγκύους
«Αυτό που φοβόμαστε όλοι είναι οι…

Τέμπη: Έως 15 τόνοι εύφλεκτου υλικού υπήρχαν στο τρένο, πολλοί θάνατοι οφείλονται στη φωτιά – Τι έδειξε νέα έκθεση
Ελένη Καρανικόλα Κοντορούση
Η επικαιροποιημένη…

Η κυβερνοασφάλεια στο επίκεντρο των δράσεων της ΕΕ.
Οι πολίτες νιώθουν ανασφαλείς από…

The JFK Assassination Chokeholds που αναπόφευκτα αποδεικνύουν ότι υπήρχε συνωμοσία….
Κατά τη διάρκεια της πολυετούς διδασκαλίας…

Τουρκία: Ετοιμάζεται νόμος για τους «πράκτορες επιρροής»
Το τουρκικό κοινοβούλιο αναμένεται…

Ενισχύεται ο Ρόλος του Ιράν στον Διεθνή Ενεργειακό και Γεωπολιτικό Καμβά
Μπορεί το Ιράν να μην αποτελεί τον…

Play-off: Μια ανάσα από το πρωτάθλημα ο ΠΑΟΚ
Μόλις 90′ μακριά από το πρωτάθλημα…

Διεθνή Διάσκεψη συνδιοργανώνουν Τσίπρας και Ζάεφ στην επέτειο της Συμφωνίας των Πρεσπών
Το «Ινστιτούτο Αλέξη Τσίπρα» και…





